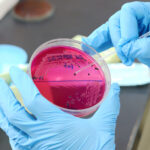
Athens Kallithea, μεταγραφές: Κοντά σε Παμλίδη, ρώτησε για Ντοναρούμα

Athens Kallithea, μεταγραφές: Κοντά σε Παμλίδη, ρώτησε για Ντοναρούμα

Η Athens Kallithea επιστρέφει στην πρώτη κατηγορία του ελληνικού πρωταθλήματος με τη διοίκηση να δουλεύει την ενίσχυση του ρόστερ. Προχωρημένο του Παμλίδη, κοιτάζει προς Ιταλία για τερματοφύλακα. Ποδόσφαιρο